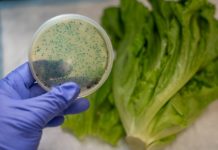

Ученые применяют свойства костей для укрепления искусственных материалов
Наше обновленное понимание того, как на самом деле работает костная ткань в самом деле может вскоре стать главным преимуществом при составлении действительно уникальны...
OnePlus призналась, что данные тысяч пользователей были украдены по её вине
Безопасность данных это безусловно очень важно, и крайне неприятно, когда её кто-то по какой-то причине нарушает. В современном мире, когда очень многое делается напрям...
В сети появились первые концепты Galaxy S11
Пожалуй на свете нет ничего более предсказуемого и постоянного, нежели ежегодный регулярный релиз новых флагманских смартфонов от Apple и Samsung. И не успели мы с вами...
В США салат ромен стал опасным источником E. Coli
Примерно неделю тому назад, Федеральная Комиссия по надзору за качеством пищевых продуктов и медикаментов США выпустила заявление о том, что потребителям стоит быть ос...
Специалисты готовят уникальный AR-шлем Jarvish
Разработки в сфере специальных аксессуаров и устройств так или иначе ведутся активными темпами – однако некоторые компании удивляют больше, чем кто-либо еще. Например,...
Робото-платформа ANYmal уже показывает себя в деле
Четвероногие роботы уже долгое время тому назад стали наиболее распространенным стандартом прикладной и специальной робототехники – однако стоит заметить тот факт, что...
Ученые выявили новый антибиотик в борьбе с синдромом Альцгеймера
Борьба с различными видами и формами нейродегенеративных заболеваний продолжается уже достаточно длительное время, а потому можно предполагать, что рано или поздно уче...
Создан новый девайс для прослушивания легких
Одним из наиболее видимых и очевидных симптомов хронической сердечной недостаточности является высокая концентрация жидкости в легких. Таким образом, чтобы получить де...
Microsoft снова позволили сотрудничать с Huawei
Все мы с вами прекрасно понимаем тот факт, что от торговой войны между Соединёнными Штатами Америки и Китаем, в частности корпорацией Huawei, очень сильно пострадали не...
Женщины чаще чем мужчины говорят «спасибо» и «пожалуйста» голосовым помощникам
Крупный и авторитетный исследовательский центр, Исследовательский центр Пью, провёл своё очередное, но на этот раз довольно необычное и неожиданное наблюдение. Его цель...